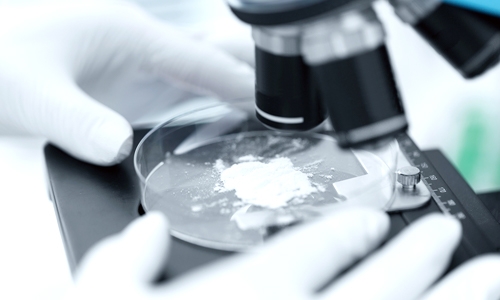
年齢によるイライラにも作用するよう精油にも徹底的に拘りました

【美容の決定版】水を使用していない北海道産の100%原液プラセンタがついに登場!
2021年3月14日新登場! 化粧品、健康補助食品の企画、製造、販売会社(運営会社:PLA LAB HOKKAIDO 株式会社、プララボ ホッカイドウ)は、「プラセンタストーリー プレミアムセラム」を発売。北海道の安全性と衛生環境を兼ね備えた養豚場生まれの高品質の「プラセンタストーリー プレミアムセラム」は、オンラインでお求めいただけます。
水を1滴も含まない贅沢な美容液。北の大地の恵みを余すことなく凝縮。

「プラセンタストーリー プレミアムセラム」は、肌への年齢ケア※を目指し、成分にこだわった美容液。水を一滴も入れず、贅沢な美容成分のみで作った至極の製品です。プラセンタ特有の臭いを感じることなく、豊かな植物の香りを楽しみながらスキンケアをお楽しみいただけます。
※年齢に応じたケア
アロマとフレグランスの効果を美容液に詰め込んだ逸品
アロマコーディネイターとフレグランスコーディネイターの資格を持つ開発者が、「女性特有のイライラやストレスを香りでケアできないか」という発想から開発。
プラセンタは、豚プラセンタ(胎盤)特有の臭いが苦手な方が多く、原液を使用しづらいという声も耳にします。そこで、香りのプロである開発者が植物由来の精油を贅沢に配合。女性の美しさや元気に役立つ成分をプラスしました。プラセンタの原液とは思えないほどの豊かで華やかな香りが魅力です。

他社の追随を許さぬ 6つのポイント

1 無添加・高濃度プラセンタ原液
2 独自の製造工程により「栄養素をそのまま」を徹底
3 徹底した低温処理。殺菌・加熱の低温処理を徹底
4 契約農家からの高品質な胎盤のみを使用
5 プラセンタ+サイタイ100%を丸ごと使用
6 ノーベル賞受賞成分「EGF」含有
北海道産100%非分解プラセンタ原液
北海道産100%の非分解プラセンタ原液です。防腐剤や鉱物油など肌に不要な成分は一切排除。水を一滴も添加せず、美容液原液100%使用。お肌にすーっとなじみ素早く浸透※。乾燥や小ジワが気になる部分に届きます。※角質層まで

こんな方におすすめします。
・肌年齢が気になり始めた方
・ハリ、ツヤが気になる方
・100%プラセンタ原液を使用したい方
・乾燥や小ジワが気になる方
・香りで癒されたい方
・イライラなどストレスを感じやすい方
【全成分表示】
プラセンタエキス、ベンチレングリコール、フェチネルアルコール、マヨラナ花/葉/茎油/ホップ花エキス、セイヨウカノコソウ根油
ご購入はオンラインストアで
<オンラインショップ>
北海道産プラセンタサプリメント
内容量:30ml
価格:22,000円(税込)/1本
販売元:PLA LAB HOKKAIDO 株式会社
https://www.plalab-hokkaido.co.jp/product.html